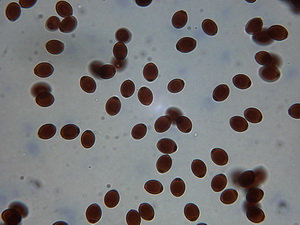

Leucocoprinus birnbaumii
Leucocoprinus birnbaumii (Corda) Singer, Sydowia 15(1-6): 67 (1962) [1961]
Leucocoprinus birnbaumii
Fund aus 1989
Fund aus 1989
Leucocoprinus spec.
Fund vom 06.09.2018
Fund vom 06.09.2018
Bei der Gegenüberstellung der Mikrobilder wurden die gleichen Maßstäbe verwendet.
Die Mikromerkmale zu L.birnbaumii stimmen mit den meisten Beschreibungen gut überein!
Die als Synonym eingestuften Arten
Leucocoprinus flos-sulphuris (Schnizl.) Cejp 1948
und
Leucocoprinus luteus (Bolton) Locq. 1945
werden in der Literatur zu Leucocoprinus birnbaumii gestellt.
Ich habe meinen Fund hier vorerst als eine "Leucocoprinus spec." eingestuft!
-
L.birnbaumii scheint meist kräftiger gefärbt
-
Die doppelt so breiten Velumverhältnisse links sind deutlich erkennbar, recht ohne ovale oder rundliche Zellen, eine Sphaerozyste gesehen!
Die Cheilozystiden rechts sind deutlich größer als links
-
Die Basidien sind unterschiedlich in ihrer Form, links keulig, rechts zylindrisch
-
Die Sporenform ist sehr unterschieden zur Unterscheidung sind Werte zu Sporengrößen nicht aussagekräftig, wohl aber der Quotient
Der Porus ist sehr unterschieden
links 0,8 - 1,2 µm groß
rechts 0,7 - 0.9 µm groß
links oft deutlich vorgewölbt
-
Der Sp.- Quotient ist unterschieden
Links Q. = 1.68 - 1.74
rechts Q. = 1.32 - 1.38
-
Sporenform, Porusgöße und
Sp.- Quotient ist sehr unterschieden
-
Stielbbekleidung nur aus putzleartigen Zellen wie auf dem Hut, ohne rundiche oder ovale Teile
Es ist mir nicht gelungen, diese blaßgelbe Leucocoprinus spec. im Vergleicht einer anderen Art zuzuordnen.
L.birnbaumii gefunden 1989 in Mönchengladbach MTB 4804/2 im Blumentopf von Yucca Palme, Wohnzimmer, Webschulstr.50,
Die Mikros stammen von ausgewachsenen ausgereiften Frk. aus 1989,
Die Mikros stammen von ausgewachsenen ausgereiften Frk. aus 1989,
leg. & det. H.Bender